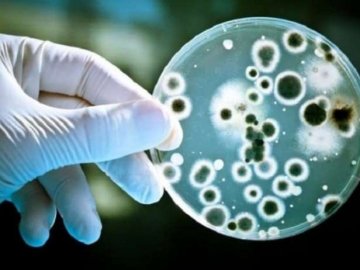

На Полтавщині зафіксували випадок гарячки Західного Нілу
Мешканцю Зіньківського району Полтавської області встановили діагноз «гарячка Західного Нілу».
У захворілого підвищилась температури тіла до 39 ०С, з’явилися слабкість, ломота в м’язах. Хворий був оглянутий сімейним лікарем та госпіталізований, - інформує Центр громадського здоров’я України.
Вірусологічною референс–лабораторією ДУ «Центру громадського здоров’я МОЗ України» методом імунофлюоресценції виявили антитіла IgG до вірусу Західного Нілу.
Станом на 27 серпня 2020 року Європейський центр профілактики та контролю захворювань (ECDC) повідомляє про 122 випадки зараження, десять людей померли: Греція (54, зокрема вісім смертей), Іспанія (44, зокрема дві смерті), Італія (22) та Румунія (дві). В Іспанії (провінція Севілья) триває спалах цієї хвороби.
В Україні існують ензоотичні території для гарячки Західного Нілу.
Вакцини для профілактики гарячки Західного Нілу не існує.
Інфікована людина не заразна. Поки немає документального підтвердження випадків передавання вірусу від людини до людини за умови дотримання стандартних заходів інфекційного контролю.
Бажаєте дізнаватися головні новини Луцька та Волині першими? Приєднуйтеся до нашого каналу в Telegram!
У захворілого підвищилась температури тіла до 39 ०С, з’явилися слабкість, ломота в м’язах. Хворий був оглянутий сімейним лікарем та госпіталізований, - інформує Центр громадського здоров’я України.
Вірусологічною референс–лабораторією ДУ «Центру громадського здоров’я МОЗ України» методом імунофлюоресценції виявили антитіла IgG до вірусу Західного Нілу.
Станом на 27 серпня 2020 року Європейський центр профілактики та контролю захворювань (ECDC) повідомляє про 122 випадки зараження, десять людей померли: Греція (54, зокрема вісім смертей), Іспанія (44, зокрема дві смерті), Італія (22) та Румунія (дві). В Іспанії (провінція Севілья) триває спалах цієї хвороби.
В Україні існують ензоотичні території для гарячки Західного Нілу.
Вакцини для профілактики гарячки Західного Нілу не існує.
Інфікована людина не заразна. Поки немає документального підтвердження випадків передавання вірусу від людини до людини за умови дотримання стандартних заходів інфекційного контролю.
Бажаєте дізнаватися головні новини Луцька та Волині першими? Приєднуйтеся до нашого каналу в Telegram!
Якщо Ви зауважили помилку, виділіть її та натисніть Ctrl+Enter для того, щоб повідомити про це редакцію
Коментарі 0
Останні новини
Відомо, в якій школі Луцька в учня виявили коронавірус
08 вересня, 2020, 18:16
Волинські учасники АТО/ООС отримали понад пів тисячі гектарів землі від початку року
08 вересня, 2020, 17:50
На Полтавщині зафіксували випадок гарячки Західного Нілу
08 вересня, 2020, 17:36
У «Промені» працює хімчистка*
08 вересня, 2020, 17:32
Скільки Волинь заробила під час сезону заготівлі ягід і грибів
08 вересня, 2020, 17:25




